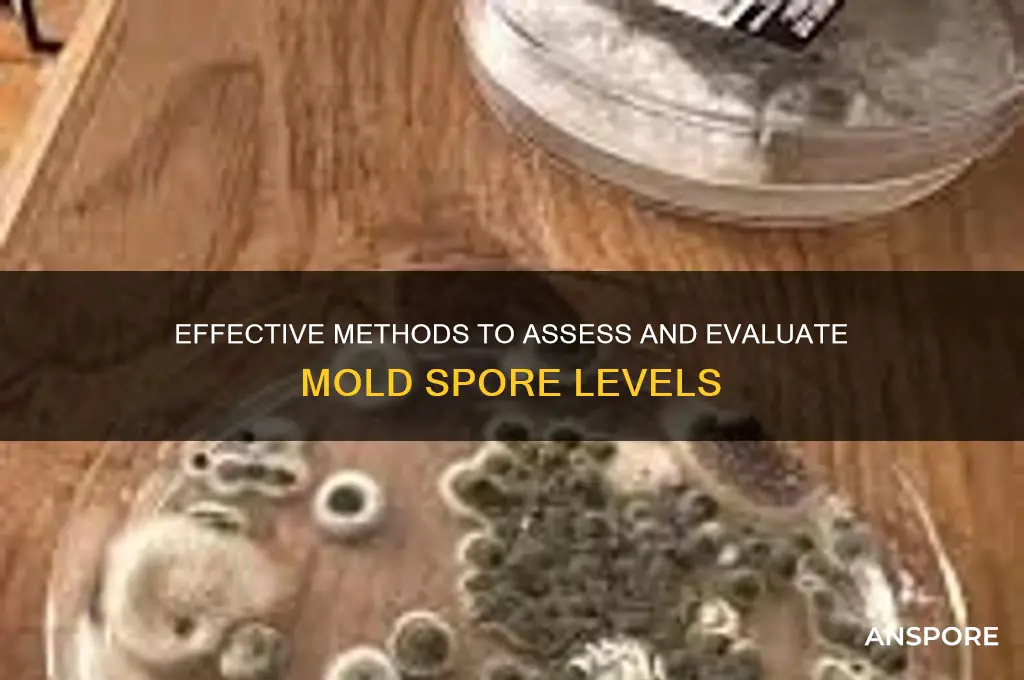
how to evaluate mold spore levels

Evaluating mold spore levels is a critical process for assessing indoor air quality and identifying potential health risks associated with mold exposure. This involves using specialized tools such as spore traps, air pumps, and microscopy to collect and analyze airborne mold particles. Key steps include selecting appropriate sampling locations, ensuring proper equipment calibration, and following standardized protocols for sample collection and laboratory analysis. Results are typically compared against baseline data or established thresholds to determine if mold levels are within acceptable limits. Understanding these methods is essential for homeowners, professionals, and health experts to mitigate mold-related issues effectively.
Explore related products
What You'll Learn
- Sampling Methods: Air, surface, and bulk sampling techniques for accurate mold spore collection
- Laboratory Analysis: Microscopic and DNA-based methods to identify and quantify spores
- Threshold Limits: Understanding acceptable spore levels based on health and safety guidelines
- Environmental Factors: Impact of humidity, temperature, and ventilation on spore concentration
- Interpretation of Results: Analyzing data to assess risk and determine remediation needs

Sampling Methods: Air, surface, and bulk sampling techniques for accurate mold spore collection
Accurate mold spore evaluation hinges on selecting the right sampling method for the situation. Air sampling, for instance, is ideal for identifying airborne mold spores and assessing overall indoor air quality. This method involves using a spore trap or air pump to collect a measured volume of air onto a prepared slide or cassette. The collected sample is then analyzed under a microscope to quantify spore types and concentrations. Air sampling is particularly useful in cases where mold growth is suspected but not visibly apparent, as it can detect hidden mold sources. However, it requires careful placement of the sampler to ensure representative results, typically at breathing height and in areas of concern.
Surface sampling, on the other hand, targets visible mold growth or suspected contaminated areas. This technique includes tape lifts, swabs, and bulk samples. Tape lifts involve pressing a piece of clear adhesive tape onto the surface and lifting it to transfer spores for microscopic examination. Swabs are used to collect mold from surfaces by moistening a sterile swab and rubbing it over the area, which is then cultured or analyzed directly. Bulk sampling involves physically removing a piece of material (e.g., drywall, carpet) for laboratory testing. Surface sampling is straightforward but limited to accessible areas and may not reflect airborne spore levels. It’s best used in conjunction with air sampling for a comprehensive assessment.
Bulk sampling is the most invasive but often the most definitive method, as it provides a direct sample of the mold-contaminated material. This technique is particularly useful for identifying the mold species and extent of infestation within building materials. For example, a piece of water-damaged drywall can be sent to a lab for culturing or DNA analysis. While bulk sampling provides concrete evidence of mold presence, it requires destructive removal of materials, making it less practical for initial assessments. It’s typically reserved for confirming the source of mold or determining the scope of remediation needed.
Each sampling method has its strengths and limitations, and the choice depends on the specific goals of the assessment. Air sampling is essential for understanding airborne spore levels, surface sampling targets visible mold, and bulk sampling provides definitive material analysis. For instance, in a residential setting with musty odors but no visible mold, air sampling would be the first step. If mold is visible on a bathroom ceiling, surface sampling via tape lifts or swabs would be appropriate. In a case of recurring mold growth in a basement, bulk sampling of the affected walls could identify the root cause. Combining these methods often yields the most accurate and actionable data for mold remediation.
Practical tips for successful sampling include maintaining chain of custody for samples, avoiding sampling during or immediately after cleaning activities, and ensuring proper calibration of air sampling equipment. For air sampling, run the pump for 5–10 minutes in each location, aiming for a total volume of 75 liters to balance accuracy and time efficiency. For surface sampling, use sterile tools and handle samples carefully to prevent contamination. Always consult a certified industrial hygienist or mold remediation specialist for complex cases, as misinterpretation of results can lead to ineffective or unnecessary remediation efforts. By understanding and applying these sampling techniques, professionals and homeowners alike can accurately evaluate mold spore levels and take informed steps toward healthier indoor environments.
Vinegar and Hydrogen Peroxide: Effective Mold Spores Killer?
You may want to see also

Laboratory Analysis: Microscopic and DNA-based methods to identify and quantify spores
Mold spore evaluation often begins with laboratory analysis, a precise and controlled environment where microscopic and DNA-based methods reveal detailed insights. Microscopic examination, the traditional approach, involves collecting samples via air pumps or surface swabs, staining them with dyes like lactophenol cotton blue, and observing under a compound microscope. Technicians identify spores by morphology—shape, size, and color—using taxonomic keys or atlases. For instance, *Aspergillus* spores appear as conidia in chains, while *Stachybotrys* spores are dark and globose. This method is cost-effective and rapid but relies on the analyst’s expertise and can misidentify fragmented or degraded spores. Quantification occurs by counting spores per unit area or volume, with results reported as colony-forming units (CFUs) or spores per cubic meter.
DNA-based methods, such as polymerase chain reaction (PCR) and sequencing, offer a molecular alternative with higher specificity and sensitivity. These techniques detect mold DNA in samples, even at low concentrations or when spores are non-viable. PCR amplifies target DNA sequences, allowing identification of species or genera through comparison with genetic databases. For example, quantitative PCR (qPCR) can quantify *Penicillium* spores in indoor air samples with precision down to 10 spores per cubic meter. DNA sequencing, particularly next-generation sequencing (NGS), provides a comprehensive profile of fungal communities, useful in complex environments like water-damaged buildings. However, these methods require specialized equipment, trained personnel, and longer processing times, making them more expensive than microscopy.
A comparative analysis highlights the strengths and limitations of each method. Microscopy excels in rapid, on-site assessments and is ideal for preliminary screenings or resource-limited settings. DNA-based methods, however, are indispensable for identifying cryptic or toxic molds like *Stachybotrys chartarum*, which may evade visual detection. Combining both approaches—using microscopy for initial quantification and DNA analysis for confirmation—yields the most robust results. For instance, a study comparing microscopy and qPCR for indoor mold assessment found that qPCR detected 30% more species, particularly in low-spore environments.
Practical tips for effective laboratory analysis include proper sample collection to avoid contamination—use sterile swabs, seal cassettes immediately, and store samples at 4°C until processing. For microscopy, ensure slides are clean and stains are fresh to prevent artifacts. In DNA analysis, inhibit substance carryover by using filter tips and dedicated PCR hoods. When interpreting results, correlate spore counts with environmental conditions (e.g., humidity levels) and health symptoms for actionable insights. Laboratories should adhere to standards like ISO 16000-18 for air sampling and ISO 18593 for DNA analysis to ensure accuracy and comparability.
In conclusion, laboratory analysis of mold spores through microscopic and DNA-based methods provides complementary tools for identification and quantification. While microscopy remains accessible and efficient, DNA techniques offer unparalleled precision, especially in complex cases. By understanding their unique advantages and limitations, professionals can tailor their approach to specific needs, ensuring reliable data for mold remediation and health risk assessments.
Understanding Sporangia: How Do They Produce and Release Spores?
You may want to see also

Threshold Limits: Understanding acceptable spore levels based on health and safety guidelines
Mold spore levels in indoor environments are not inherently dangerous, but exceeding certain thresholds can pose health risks, particularly for vulnerable populations. Health and safety guidelines, such as those from the World Health Organization (WHO) and the Environmental Protection Agency (EPA), establish acceptable limits to minimize adverse effects. For instance, the EPA recommends that indoor mold spore counts should not exceed outdoor levels by more than 10-20%. This baseline ensures that indoor air quality remains within a safe range, as outdoor spore counts are generally considered natural and tolerable.
Understanding these thresholds requires knowledge of specific spore types and their associated health risks. For example, *Stachybotrys chartarum* (black mold) is particularly harmful due to its production of mycotoxins, which can cause severe respiratory issues and neurological symptoms. Guidelines often set lower thresholds for toxic molds like this, sometimes recommending immediate remediation if detected in any significant quantity. In contrast, common molds like *Cladosporium* or *Aspergillus* may have higher acceptable limits, though prolonged exposure can still trigger allergies or asthma in sensitive individuals.
Practical evaluation of spore levels involves air sampling and surface testing, often conducted by professionals using spore traps or swab cultures. Results are compared against established thresholds, which vary by region and regulatory body. For example, the American Conference of Governmental Industrial Hygienists (ACGIH) provides threshold limit values (TLVs) for specific molds, while the Institute of Inspection, Cleaning and Restoration Certification (IICRC) offers guidelines for post-remediation verification. These standards help determine whether spore counts are within acceptable limits or require intervention.
Vulnerable populations, including children, the elderly, and immunocompromised individuals, necessitate stricter adherence to threshold limits. For instance, schools and healthcare facilities often adopt more conservative guidelines to protect sensitive occupants. In residential settings, homeowners should aim for spore counts below 500 spores per cubic meter for common molds, though this may vary based on local regulations. Regular monitoring and proactive measures, such as improving ventilation and reducing humidity, are essential to maintaining levels within safe thresholds.
In conclusion, threshold limits for mold spore levels are not one-size-fits-all but depend on factors like mold type, occupant health, and regulatory standards. By understanding these guidelines and employing proper evaluation methods, individuals and organizations can ensure indoor environments remain safe and healthy. When thresholds are exceeded, prompt remediation is critical to prevent long-term health consequences and structural damage.
Should Spores Be Refrigerated? Storage Tips for Optimal Viability
You may want to see also
Explore related products

Environmental Factors: Impact of humidity, temperature, and ventilation on spore concentration
Mold spore concentration is not a static measure; it fluctuates dramatically with environmental conditions. Humidity, temperature, and ventilation act as the primary conductors of this microbial orchestra, each influencing spore proliferation, dispersal, and viability. Understanding their interplay is crucial for accurate assessment and effective mitigation.
Humidity reigns supreme in the mold kingdom. Relative humidity above 60% creates a veritable spa for spores, providing the moisture necessary for germination and growth. Think of it as a microscopic rainforest where mold thrives. Every 10% increase in humidity above this threshold can double spore counts, particularly for common indoor culprits like Cladosporium and Penicillium. Conversely, maintaining humidity below 50% through dehumidifiers or proper ventilation starves mold, significantly reducing spore levels and preventing colonization.
Temperature plays a dual role, acting as both catalyst and inhibitor. Most mold species flourish in the temperate zone of 25°C to 30°C (77°F to 86°F), mirroring the comfort range for humans. However, some molds, like Aspergillus, exhibit remarkable resilience, surviving and even sporulating at temperatures as low as 4°C (39°F). Conversely, temperatures exceeding 50°C (122°F) can effectively sterilize surfaces, killing spores and preventing growth. This knowledge is crucial for targeted remediation strategies, such as using heat treatment for localized mold infestations.
Ventilation acts as the invisible hand, dictating spore dispersal and dilution. Poor ventilation traps spores indoors, allowing them to accumulate and reach problematic levels. Imagine a stuffy room as a petri dish, fostering mold growth and increasing spore concentration. Conversely, adequate ventilation, achieved through open windows, exhaust fans, or air exchange systems, acts as a spore vacuum, constantly diluting indoor air and preventing buildup. Aim for a minimum of 0.35 air changes per hour in living spaces to maintain healthy air quality and keep spore counts in check.
Evaluating mold spore levels requires a holistic approach that considers these environmental factors. Simply measuring spores without understanding the underlying conditions is like diagnosing a fever without considering the patient's environment. By monitoring humidity, temperature, and ventilation, we gain valuable insights into the mold ecosystem, enabling us as to pinpoint sources, predict outbreaks, and implement targeted solutions for a healthier indoor environment.
Baking and Botulism: Does Heat Destroy Spores in Honey?
You may want to see also

Interpretation of Results: Analyzing data to assess risk and determine remediation needs
Interpreting mold spore data requires a nuanced understanding of baseline levels and thresholds. Outdoor mold spores naturally fluctuate with seasons, typically ranging from 500 to 1,000 spores per cubic meter of air. Indoor levels should mirror these but at a lower concentration—ideally 50–200 spores per cubic meter. Exceeding outdoor counts by 20–30% or surpassing 500 spores indoors signals potential mold growth. For instance, if outdoor Cladosporium levels are 800 spores/m³, indoor levels above 1,000 spores/m³ warrant investigation. This comparative analysis is the first step in assessing risk.
Once data is collected, categorize spore types to gauge health risks. Allergenic molds like *Alternaria* or *Aspergillus* pose risks at moderate levels (500–1,000 spores/m³) for sensitive individuals, such as children or asthmatics. Toxic molds like *Stachybotrys* (black mold) require immediate action even at low concentrations (<100 spores/m³). For example, detecting *Stachybotrys* at 50 spores/m³ in a home with infants necessitates urgent remediation. Cross-reference findings with occupant health symptoms—respiratory issues, allergies, or skin irritation—to prioritize action.
Remediation needs are determined by both spore concentration and affected area size. Minor issues, such as localized growth (<10 sq. ft.) with spore counts under 1,000/m³, may require DIY solutions like HEPA vacuuming and mold-killing cleaners. Moderate cases (10–30 sq. ft. or 1,000–5,000 spores/m³) demand professional intervention, including containment and air scrubbing. Severe infestations (>30 sq. ft. or >5,000 spores/m³) often involve structural repairs and specialized equipment. Always follow EPA guidelines, such as using N-95 respirators during cleanup to prevent spore inhalation.
Caution must be exercised when interpreting inconclusive or conflicting data. False negatives can occur if sampling misses hidden mold, while false positives may arise from outdoor contamination. Repeated testing over 24–48 hours provides clarity. For example, if initial results show elevated *Penicillium* levels but no visible mold, test again after closing windows and doors to eliminate outdoor influence. Consult certified industrial hygienists for ambiguous cases, as misinterpreting data can lead to unnecessary costs or health risks.
The ultimate goal of interpretation is actionable insight. Combine quantitative data with qualitative observations—musty odors, water stains, or visible growth—to create a comprehensive risk profile. For instance, a basement with 1,500 *Aspergillus* spores/m³, a leaky pipe, and peeling paint indicates both active mold and ongoing moisture issues. Remediation should address both the mold and the source of moisture. Regular post-remediation testing ensures effectiveness, with spore counts returning to baseline levels within 2–4 weeks. This systematic approach transforms raw data into a roadmap for a healthier environment.
Assessing Bacillus Subtilis Spores Viability: A Comprehensive Testing Guide
You may want to see also
Frequently asked questions
The most common methods include air sampling using spore traps, which collect airborne spores for laboratory analysis, and surface sampling via swabs or tape lifts to test visible mold growth. Additionally, ERMI (Environmental Relative Moldiness Index) testing and PCR (polymerase chain reaction) analysis are advanced techniques used for detailed mold assessments.
Mold spore levels should be evaluated if there are signs of water damage, musty odors, or health concerns. Routine testing is recommended annually for high-risk environments (e.g., humid climates or buildings with a history of mold). After remediation, testing should be conducted to ensure mold levels have returned to normal.
There is no universally accepted threshold for mold spore levels, as it depends on the types of mold present and the specific environment. However, indoor spore counts should generally be lower than outdoor counts. If indoor levels are significantly higher or if toxic molds (e.g., Stachybotrys) are detected, professional remediation is advised.
DIY mold test kits are available, but they often lack accuracy and cannot identify specific mold types. For reliable results, especially in cases of suspected mold issues, hiring a certified mold inspector or industrial hygienist is recommended. Professionals use specialized equipment and interpret results based on industry standards.































